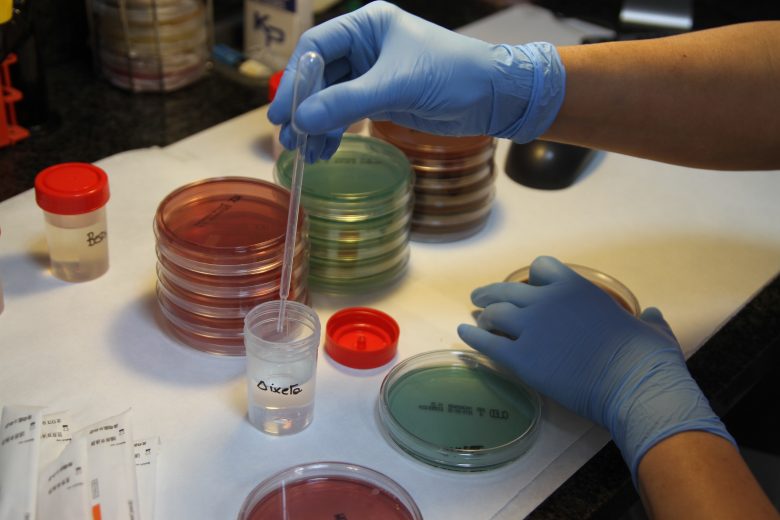

Faircap at the Barcelona Maker Faire
Attending the Maker Faire in Silicon Valley back in 2014 was one of the key moments that inspired the Faircap project. Realizing that anyone could make something creative, technologically advanced or useful stuff in their garage, college, school or home was very empowering.